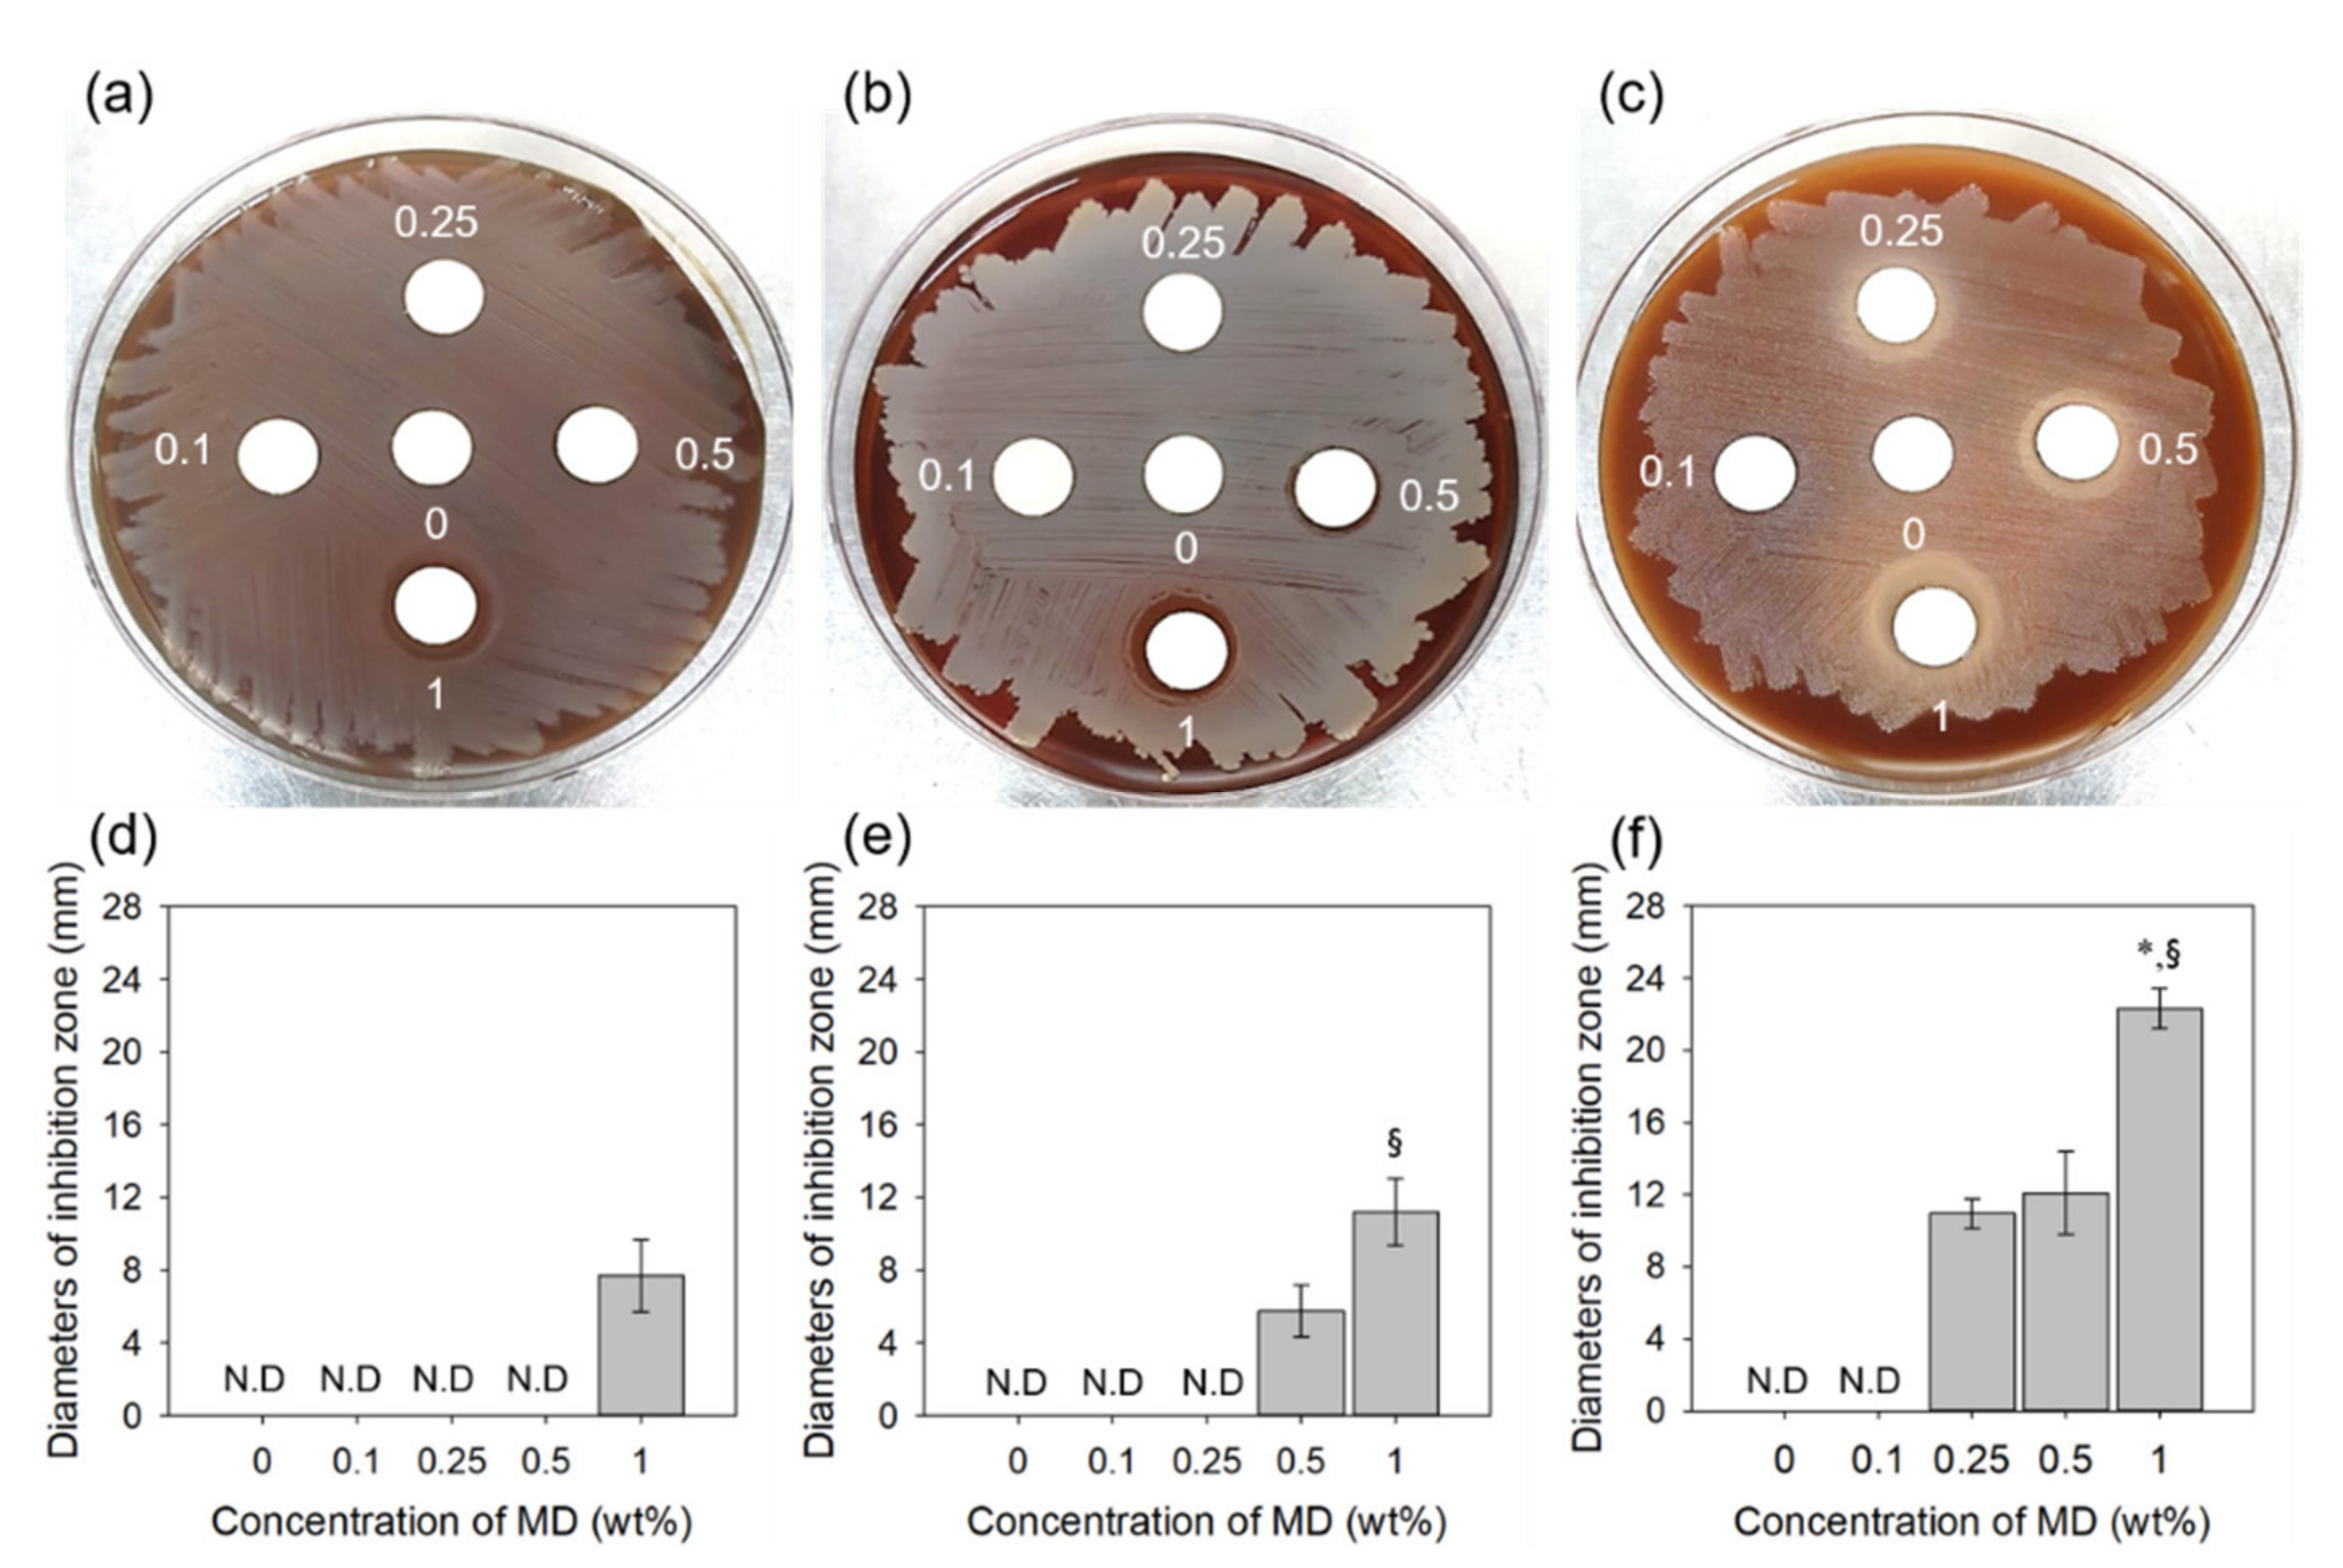

Preparation of Radiation Cross-Linked Poly(Acrylic Acid) Hydrogel Containing Metronidazole with Enhanced Antibacterial Activity
Abstract
1. Introduction
2. Results and Discussion
2.1. Characterization of Iradiated MD
2.2. Characterization of MD/PAA
2.3. In Vitro Cytocompatibility of MD/PAA
2.4. Release Test of MD/PAA
2.5. Anti-Bacterial Activity Test
3. Materials and Methods
3.1. Materials
3.2. Exposure of Metronidazole by Gamma-Ray
3.3. Preparation of Metronidazole Containing Poly (acrylic acid) Films Using Gamma-Ray
3.4. Chemical Structure
3.5. Characteristic of Hydrogel
3.6. In Vitro Cytocompatibility Test
3.7. Release Test
3.8. Anti-Bacterial Activity Test
3.9. Statistical Analysis
4. Conclusions
Supplementary Materials
Author Contributions
Funding
Conflicts of Interest
References
- Johnson, M.B.; Mehrvar, M. Aqueous Metronidazole Degradation by UV/H2O2 Process in Single-and Multi-Lamp Tubular Photoreactors: Kinetics and Reactor Design. Ind. Eng. Chem. Res. 2008, 47, 6525–6537. [Google Scholar] [CrossRef]
- Shemer, H.; Kunukcu, Y.K.; Linden, K.G. Degradation of the pharmaceutical Metronidazole via UV, Fenton and photo-Fenton processes. Chemosphere 2006, 63, 269–276. [Google Scholar] [CrossRef]
- Khan, G.; Yadav, S.K.; Patel, R.R.; Nath, G.; Bansal, M.; Mishra, B. Development and Evaluation of Biodegradable Chitosan Films of Metronidazole and Levofloxacin for the Management of Periodontitis. AAPS PharmSciTech 2016, 17, 1312–1325. [Google Scholar] [CrossRef] [PubMed]
- Dahlen, G.; Preus, H.R. Low antibiotic resistance among anaerobic Gram-negative bacteria in periodontitis 5 years following metronidazole therapy. Anaerobe 2017, 43, 94–98. [Google Scholar] [CrossRef] [PubMed]
- Pichayakorn, W.; Boonme, P. Evaluation of cross-linked chitosan microparticles containing metronidazole for periodontitis treatment. Mater. Sci. Eng. C Mater. Biol. Appl. 2013, 33, 1197–1202. [Google Scholar] [CrossRef] [PubMed]
- Meng, L.; Yin, J.; Yuan, Y.; Xu, N. Near-infrared fluorescence probe: BSA-protected gold nanoclusters for the detection of metronidazole and related nitroimidazole derivatives. Anal. Methods 2017, 9, 768–773. [Google Scholar] [CrossRef]
- Reinholz, J.; Landfester, K.; Mailänder, V. The challenges of oral drug delivery via nanocarriers. Drug Deliv. 2018, 25, 1694–1705. [Google Scholar] [CrossRef]
- Miranda, D.G.; Malmonge, S.M.; Campos, D.M.; Attik, N.G.; Grosgogeat, B.; Gritsch, K. A chitosan-hyaluronic acid hydrogel scaffold for periodontal tissue engineering. J. Biomed. Mater. Res. B Appl. Biomater. 2016, 104, 1691–1702. [Google Scholar] [CrossRef]
- Puppi, D.; Migone, C.; Grassi, L.; Pirosa, A.; Maisetta, G.; Batoni, G.; Chiellini, F. Integrated three-dimensional fiber/hydrogel biphasic scaffolds for periodontal bone tissue engineering. Polym. Int. 2016, 65, 631–640. [Google Scholar] [CrossRef]
- Francis, S.; Kumar, M.; Varshney, L. Radiation synthesis of superabsorbent poly(acrylic acid)–carrageenan hydrogels. Radiat. Phys. Chem. 2004, 69, 481–486. [Google Scholar] [CrossRef]
- Qiao, K.; Guo, S.; Zheng, Y.; Xu, X.; Meng, H.; Peng, J.; Fang, Z.; Xie, Y. Effects of graphene on the structure, properties, electro-response behaviors of GO/PAA composite hydrogels and influence of electro-mechanical coupling on BMSC differentiation. Mater. Sci. Eng. C 2018, 93, 853–863. [Google Scholar] [CrossRef] [PubMed]
- Jabbari, E.; Nozari, S. Swelling Behaviour of Acrylic Acid Hydrogels Prepared by??-Radiation Crosslinking of Polyacrylic Acid in Aqueous Solution. Eur. Polym. J. 2000, 36, 2685–2692. [Google Scholar] [CrossRef]
- Broom, N.D.; Oloyede, A. The importance of physicochemical swelling in cartilage illustrated with a model hydrogel system. Biomaterials 1998, 19, 1179–1188. [Google Scholar] [CrossRef]
- Scotchford, C.A.; Cascone, M.G.; Downes, S.; Giusti, P. Osteoblast responses to collagen-PVA bioartificial polymers in vitro: The effects of cross-linking method and collagen content. Biomaterials 1998, 19, 1–11. [Google Scholar] [CrossRef]
- Hassan, S.; Yasin, T. Synthesis of radiation crosslinked poly(acrylic acid) in the presence of phenyltriethoxysilane. Radiat. Phys. Chem. 2014, 97, 292–297. [Google Scholar] [CrossRef]
- Rosiak, J.M.; Ulański, P. Synthesis of hydrogels by irradiation of polymers in aqueous solution. Radiat. Phys. Chem. 1999, 55, 139–151. [Google Scholar] [CrossRef]
- Qi, X.; Hu, X.; Wei, W.; Yu, H.; Li, J.; Zhang, J.; Dong, W. Investigation of Salecan/poly(vinyl alcohol) hydrogels prepared by freeze/thaw method. Carbohydr. Polym. 2015, 118, 60–69. [Google Scholar] [CrossRef]
- Huang, X.; Zhang, Y.; Zhang, X.; Xu, L.; Chen, X.; Wei, S. Influence of radiation crosslinked carboxymethyl-chitosan/gelatin hydrogel on cutaneous wound healing. Mater. Sci. Eng. C Mater. Biol. Appl. 2013, 33, 4816–4824. [Google Scholar] [CrossRef]
- Demeter, M.; Virgolici, M.; Vancea, C.; Scarisoreanu, A.; Kaya, M.G.A.; Meltzer, V. Network structure studies on γ–irradiated collagen–PVP superabsorbent hydrogels. Radiat. Phys. Chem. 2017, 131, 51–59. [Google Scholar] [CrossRef]
- Fekete, T.; Borsa, J.; Takács, E.; Wojnárovits, L. Synthesis of cellulose derivative based superabsorbent hydrogels by radiation induced crosslinking. Cellulose 2014, 21, 4157–4165. [Google Scholar] [CrossRef]
- Al-qudah, Y.H.F.; Mahmoud, G.A.; Abdel Khalek, M.A. Radiation crosslinked poly (vinyl alcohol)/acrylic acid copolymer for removal of heavy metal ions from aqueous solutions. J. Radiat. Res. Appl. Sci. 2014, 7, 135–145. [Google Scholar] [CrossRef]
- Nikolic, V.M.; Krkljes, A.; Popovic, Z.K.; Lausevic, Z.V.; Miljanic, S.S. On the use of gamma irradiation crosslinked PVA membranes in hydrogen fuel cells. Electrochem. Commun. 2007, 11, 2661–2665. [Google Scholar] [CrossRef]
- Yang, J.M.; Su, W.Y.; Leu, T.L.; Yang, M.C. Evaluation of chitosan/PVA blended hydrogel membranes. J. Membr. Sci. 2004, 236, 39–51. [Google Scholar] [CrossRef]
- Singh, B.; Chauhan, N.; Kumar, S. Radiation crosslinked psyllium and polyacrylic acid based hydrogels for use in colon specific drug delivery. Carbohydr. Polym. 2008, 73, 446–455. [Google Scholar] [CrossRef]
- Abd El-Rehim, H.A.; Swilem, A.E.; Klingner, A.; Hegazy, E.-S.A.; Hamed, A.A. Developing the potential ophthalmic applications of pilocarpine entrapped into polyvinylpyrrolidone-poly(acrylic acid) nanogel dispersions prepared by γ radiation. Biomacromolecules 2013, 14, 688–698. [Google Scholar] [CrossRef]
- Nho, Y.-C.; Park, J.-S.; Lim, Y.-M. Preparation of Poly(acrylic acid) Hydrogel by Radiation Crosslinking and Its Application for Mucoadhesives. Polymers 2014, 6, 890–898. [Google Scholar] [CrossRef]
- Vasi, A.-M.; Popa, M.I.; Tanase, E.C.; Butnaru, M.; Verestiuc, L. Poly(acrylic acid)-poly(ethylene glycol) nanoparticles designed for ophthalmic drug delivery. J. Pharm. Sci. 2014, 103, 676–686. [Google Scholar] [CrossRef]
- Salahuddin, A.; Agarwal, S.M.; Avecilla, F.; Azam, A. Metronidazole thiosalicylate conjugates: synthesis, crystal structure, docking studies and antiamoebic activity. Bioorg. Med. Chem. Lett. 2012, 22, 5694–5699. [Google Scholar] [CrossRef]
- Di Martino, P.; Censi, R.; Malaj, L.; Capsoni, D.; Massarotti, V.; Martelli, S. Influence of solvent and crystallization method on the crystal habit of metronidazole. Cryst. Res. Technol. 2007, 42, 800–806. [Google Scholar] [CrossRef]
- De Souza, N.A.B.; de Souza, F.S.; Basílio, I.D.; Medeiros, A.C.D.; Oliveira, E.J.; Santos, A.F.O.; Macwdo, R.O.; Macędo, R.O. Thermal stability of metronidazole drug and tablets. J. Therm. Anal. Calorim. 2003, 72, 535–538. [Google Scholar] [CrossRef]
- Singh, R.; Maity, S.; Sa, B. Effect of ionic crosslink on the release of metronidazole from partially carboxymethylated guar gum tablet. Carbohydr. Polym. 2014, 106, 414–421. [Google Scholar] [CrossRef] [PubMed]
- Park, J.-S.; An, S.-J.; Jeong, S.-I.; Gwon, H.-J.; Lim, Y.-M.; Nho, Y.-C. Chestnut Honey Impregnated Carboxymethyl Cellulose Hydrogel for Diabetic Ulcer Healing. Polymers 2017, 9, 248. [Google Scholar] [CrossRef] [PubMed]
- Xue, J.; He, M.; Liang, Y.; Crawford, A.; Coates, P.; Chen, D.; Shi, R.; Zhang, L. Fabrication and evaluation of electrospun PCL–gelatin micro-/nanofiber membranes for anti-infective GTR implants. J. Mater. Chem. B 2014, 2, 6867–6877. [Google Scholar] [CrossRef]
- Prabhakaran, M.P.; Zamani, M.; Felice, B.; Ramakrishna, S. Electrospraying technique for the fabrication of metronidazole contained PLGA particles and their release profile. Mater. Sci. Eng. C Mater. Biol. Appl. 2015, 56, 66–73. [Google Scholar] [CrossRef] [PubMed]
- Villinski, J.R.; Bergeron, C.; Cannistra, J.C.; Gloer, J.B.; Coleman, C.M.; Ferreira, D.; Azelmat, J.; Grenier, D.; Gafner, S. Pyrano-isoflavans from Glycyrrhiza uralensis with antibacterial activity against Streptococcus mutans and Porphyromonas gingivalis. J. Nat. Prod. 2014, 77, 521–526. [Google Scholar] [CrossRef]
- Eshed, M.; Lellouche, J.; Matalon, S.; Gedanken, A.; Banin, E. Sonochemical coatings of ZnO and CuO nanoparticles inhibit Streptococcus mutans biofilm formation on teeth model. Langmuir ACS J. Surf. Colloids 2012, 28, 12288–12295. [Google Scholar] [CrossRef]

| Sample | MD Content (wt%) | Radiation Dose (kGy) |
|---|---|---|
| MD/PAA25 | 1 | 25 |
| MD/PAA50 | 1 | 50 |
| MD/PAA75 | 1 | 75 |
| Sample | MD Content (wt%) | Radiation Dose (kGy) |
|---|---|---|
| 0.1MD/PAA | 0.1 | 25 |
| 0.25MD/PAA | 0.25 | 25 |
| 0.5MD/PAA | 0.5 | 25 |
| 1MD/PAA | 1 | 25 |
© 2019 by the authors. Licensee MDPI, Basel, Switzerland. This article is an open access article distributed under the terms and conditions of the Creative Commons Attribution (CC BY) license (http://creativecommons.org/licenses/by/4.0/).
Share and Cite
Jeong, J.-O.; Park, J.-S.; Kim, E.J.; Jeong, S.-I.; Lee, J.Y.; Lim, Y.-M. Preparation of Radiation Cross-Linked Poly(Acrylic Acid) Hydrogel Containing Metronidazole with Enhanced Antibacterial Activity. Int. J. Mol. Sci. 2020, 21, 187. https://doi.org/10.3390/ijms21010187
Jeong J-O, Park J-S, Kim EJ, Jeong S-I, Lee JY, Lim Y-M. Preparation of Radiation Cross-Linked Poly(Acrylic Acid) Hydrogel Containing Metronidazole with Enhanced Antibacterial Activity. International Journal of Molecular Sciences. 2020; 21(1):187. https://doi.org/10.3390/ijms21010187
Chicago/Turabian StyleJeong, Jin-Oh, Jong-Soek Park, Eui Jin Kim, Sung-In Jeong, Jae Young Lee, and Youn-Mook Lim. 2020. "Preparation of Radiation Cross-Linked Poly(Acrylic Acid) Hydrogel Containing Metronidazole with Enhanced Antibacterial Activity" International Journal of Molecular Sciences 21, no. 1: 187. https://doi.org/10.3390/ijms21010187
APA StyleJeong, J.-O., Park, J.-S., Kim, E. J., Jeong, S.-I., Lee, J. Y., & Lim, Y.-M. (2020). Preparation of Radiation Cross-Linked Poly(Acrylic Acid) Hydrogel Containing Metronidazole with Enhanced Antibacterial Activity. International Journal of Molecular Sciences, 21(1), 187. https://doi.org/10.3390/ijms21010187

